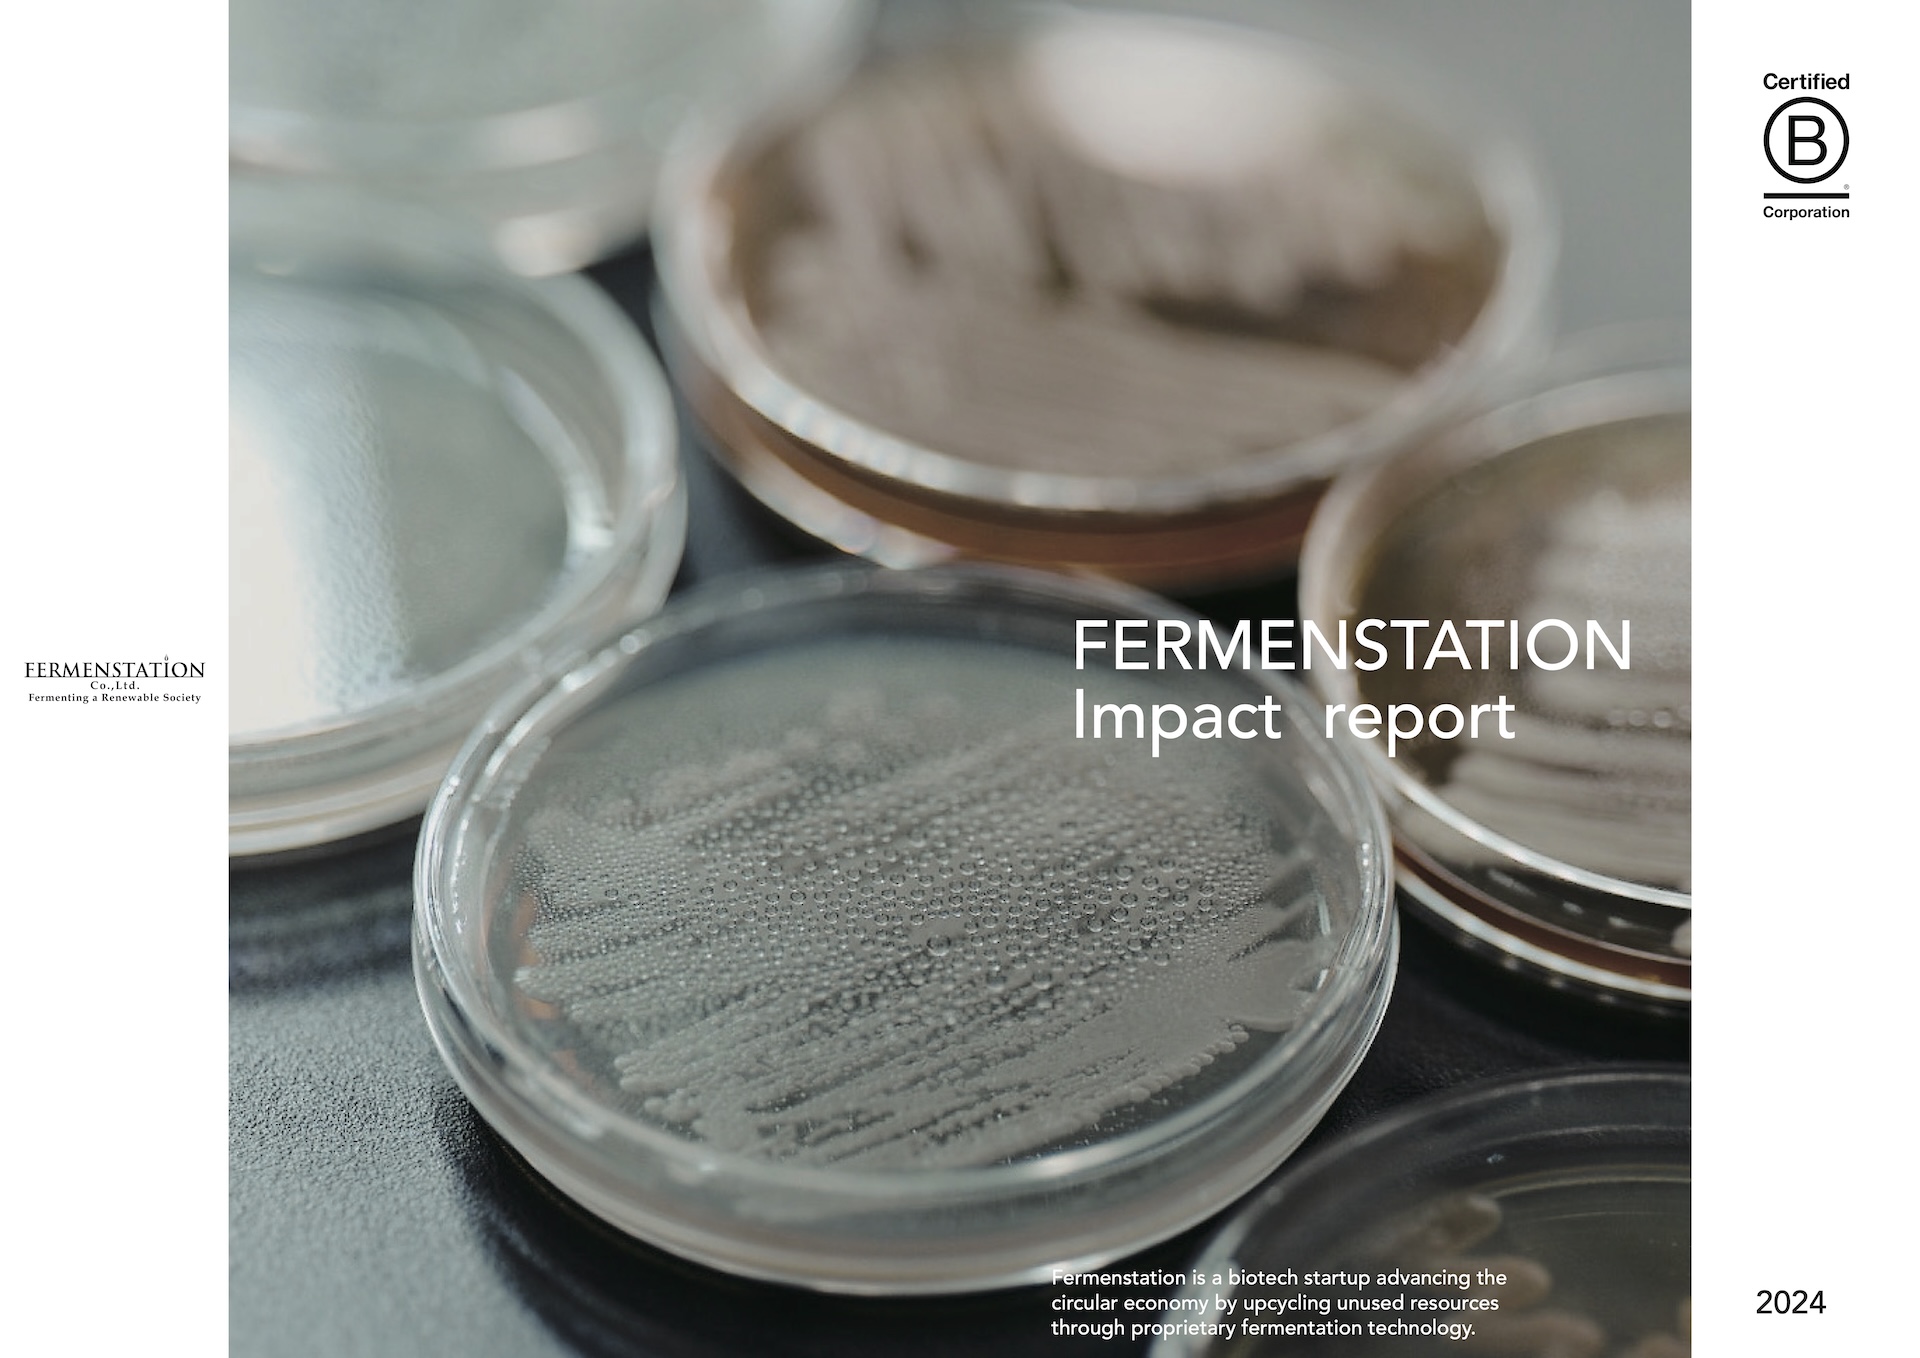
ファーメンステーション インパクトレポート

ファーメンステーション インパクトレポート
独自の発酵技術で未利用資源を価値へと転換するファーメンステーションの「Impact report 2024版」。本レポートでは理念や創業ストーリーから、取り組む社会課題、事業内容や技術、組織、年間トピックスやバリューに至るまで、同社が多面的に社会的インパクトを生み出している様子を紹介しています。
さらに同社が独自に開発した新しいインパクトモデル「インパクトモデルβ版」フェーズアップ図とシステムチェンジ図も公開。専門性が高く、高度に思考された上質な情報を、高いブランディングを保ちつつも、読み手にいかにわかりやすく伝えるかを念頭に、視覚設計からコピーライティング、原稿、デザインなど多岐に渡り、こだわりが滲み出るように意識しました。アウトプットはWEB版、印刷版に加え、同社がグローバル展開を加速させている最中ということで、英語版も併せて制作いたしました。






TEAM
- Creative Director / Writer國府田 淳RIDE
- Photographer田野英知
- Designer永壽